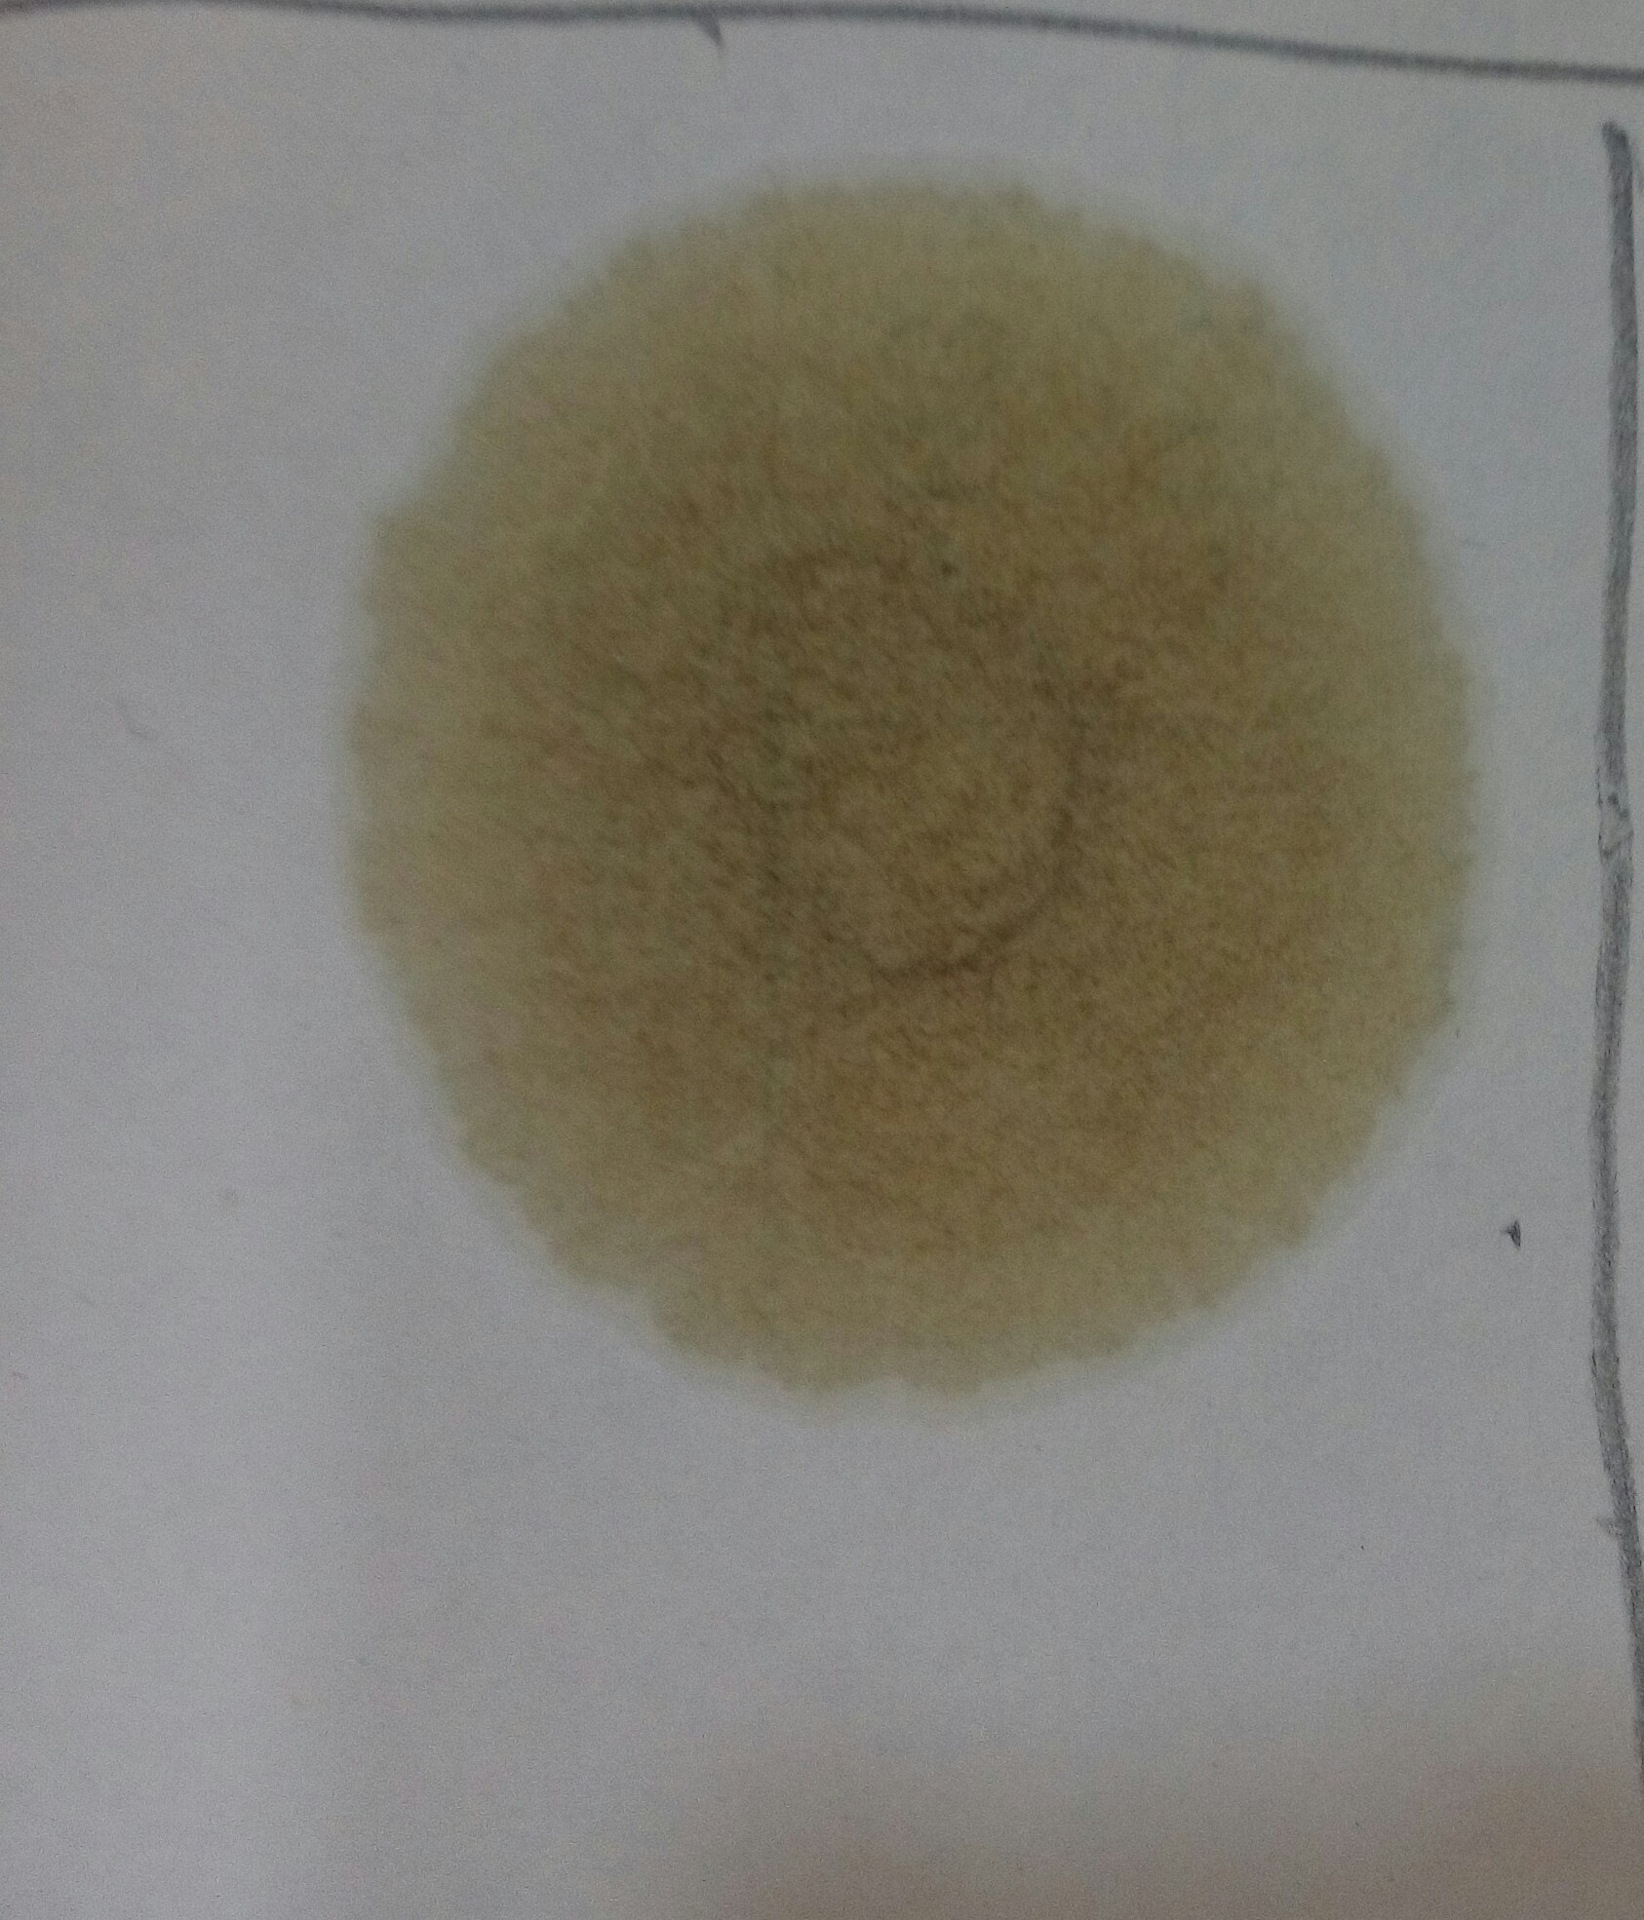

Определить масло по бумаге
Определить масло по бумаге 116 фотографий
Акция семейные книги памяти
Игра brain test 34
Супруги спят раздельно
Dyna switchback
Как одеваться туристам в оаэ
Годовое расписание поезда архангельск адлер 2025
Планеты солнечной системы песня
Тепловой двигатель с кпд 40 за цикл
Вакансии преподавателя английского языка в школе
Малыши тигрята решившие заглянуть в гости
Максимальный фпс в пабг мобайл
Спайдер буровой
Интернет версия маяк сысерть
Русско украинское население
Принуждение история рассказы
Край листа пластины
Математика 6 класс упр 1072
Холодильник pozis стеклянный
Garmin fenix 7s pro sapphire
Примеры налогового планирования